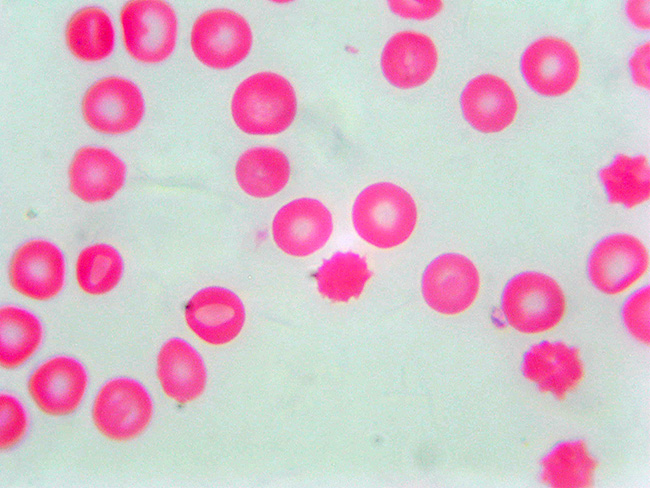

Non hai articoli nel carrello.
Microscopio biologico di elevata qualità e dal design elegante e moderno, ideale per studenti e laboratori grazie alle sue caratteristiche professionali ma ad un prezzo contenuto
Caratteristiche principali:
Testa ruotabile di 360° , inclinata a 30° con visione binoculare e coppia di oculari wide field 10x (18mm)
Revolver a 4 obbiettivi planacromatici 4x-10x-40x-100x (olio) 0.17

Condensatore di Abbe N.A. 1.25 con diaframma ad iride e supporto porta filtri
Sorgente di luce LED da 3W regolabile
Tavolo di lavoro con doppia regolazione micrometrica, dimensioni 110x125 e range di movimento 35x50mm
Messa a fuoco macro e micro da entrambi i lati, il movimento micrometrico spostata il fuoco di 0,002mm. L'escursione di fuoco è di 36mm

Globuli rossi ripresi a 500x con camera Tecnosky 5mpx
Dotazione:
Microscopio
Oculare WA10x
Telo protezione
Cavo alimentazione 220v
Olio per obbiettivo 1000x
| Codice Prodotto(SKU) | tkmicroledbino |
|---|---|
| Produttore | Tecnosky |